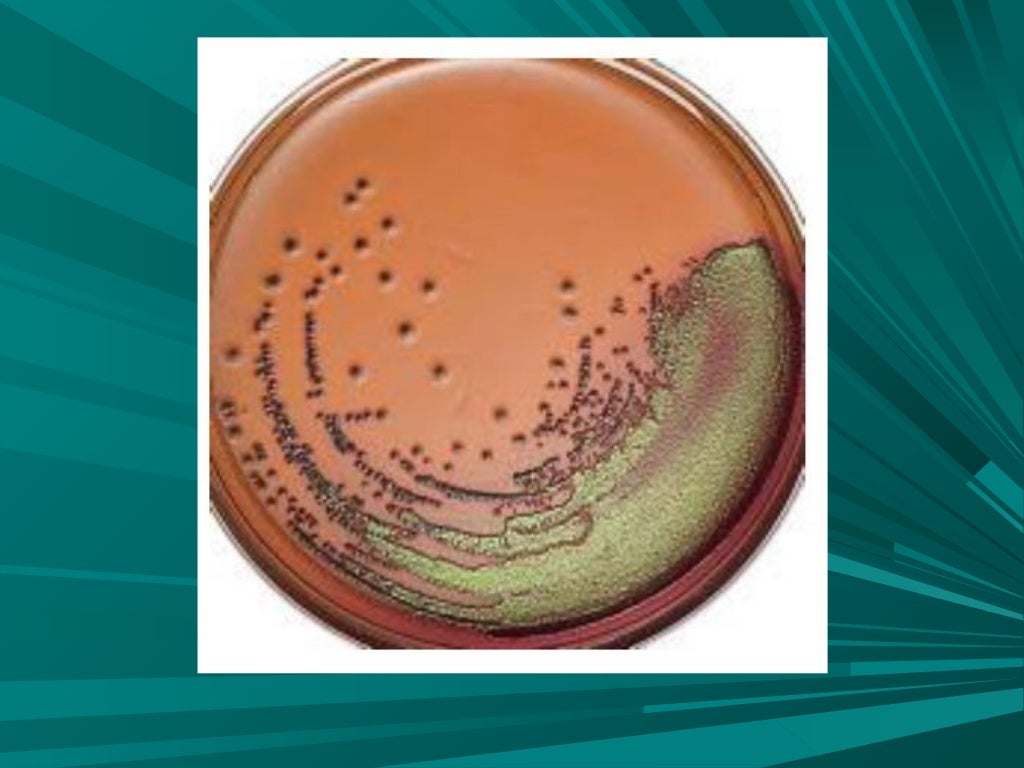

Azul De Metileno Microscópio EDUCA

El H2 cedido por el succinato puede ser transferido del FADH2 a un colorante susceptible como el azul de metileno que es un sustituyente del aceptor natural de electrones, donde actúa como reductores, que al cambiar su estado redox pasa de coloreado a incoloro o viceversa. la e Evalúa la actividad de le enzima Succinato Deshidrogenasa.
Práctica 3 Determinación de la actividad de la enzima succinato deshidrogenasa INTRODUCCIÓN
tampón Tris-HCl 2,5 mmol.l-1 (pH 7,4), 1 ml de succinato de sodio 1 % (Merck, Alemania), 0,5 ml de azul de metileno 0,01 % (Merck, Alemania) y 1 ml de extracto de C. latifolia o C. aurantiifolia a una concentración de fenoles totales de 20 mg EAG.ml-1. En los controles positivo y negativo de la respiración celular se
Práctica 3. Determinación de la actividad de la enzima succinato deshidrogenasa INTRODUCCIÓN
La succinato deshidrogenasa o succionato coenzima Q reductasa es una flavoproteína ligada a la membrana interna mitocondrial que interviene en el ciclo de Krebs y en la cadena de transporte de electrones y que contiene FAD (flavín-adenín-dinucleótido) unido covalentemente.Posee un peso molecular de alrededor de 100 kDa, y contiene una molécula de FAD, ocho átomos de hierro y ocho átomos.
AZUL DE METILENO SOLUCION 1 X 250 ML Dicorlab

Práctica 1. Determinación de la Actividad de la Enzima Succinato Deshidrogenasa. Función de cada reactivo. Azul de metileno.- Tiene la función de ser el aceptor de electrones del complejo succinato-FADH2 Ácido Succinico.- Tiene la función de reducir al azul de metileno, ya que éste es reducido en lugar del succinato. Aceite de bebé.-
Agar eosinaazul de metileno (EMB) Paginawebenfocadaenlarealizaciondecoprocultivoe
Estructuras del azul de metileno en estado oxidado y reducido; Fenol y su papel en la desnaturalización de las proteínas; Características generales del Ciclo de Krebs;. El succinato deshidrogenasa remueve 2H+ y 2 electrones del succinato para formar fumarato y la coenzima reducida FADH2. La enzima está sujeta a una poderosa inhibición.
Agar eosina azul de metileno
Además, los inhibidores de la succinato deshidrogenasa (SDIs) pueden unirse a la enzima e inhibir su actividad. Los SDIs se han utilizado como agentes terapéuticos para ciertos cánceres, pero también pueden causar la deficiencia de succinato deshidrogenasa cuando su uso resulta en una reducción de la actividad enzimática.
Succinato deshidrogenasa

Esto se debe a que el fenol inhibe la actividad de la enzima succinato deshidrogenasa, no realiza su función de oxidar al succinato, por lo que el azul de metileno no es reducido. En el tubo 3, al cual se le agregó aceite mineral y azul de metileno, se observó que adquiere una apariencia incolora.
Práctica 14. Preparar un banco de diluciones de azul de metileno 06/02/2019

Figura 2.Función de la succinato deshidrogenasa; el camino seguido por los electrones se muestra con flechas rojas. El FADH 2 de la succinato deshidrogenasa, al no poder desprenderse de la enzima, debe oxidarse nuevamente in situ.El FADH 2 cede sus dos hidrógenos a la ubiquinona que se reduce a ubiquinol (QH 2) y abandona el enzima, difundiendo en la bicapa lipídica hasta alcanzar el.
Agar Eosina y Azul de Metileno

La razón detrás de esto se debe a que el fenol inhibió la actividad de la enzima succinato deshidrogenasa. El azul de metileno generalmente se reduce en una reacción bioquímica, lo que provoca un cambio en su color. Sin embargo, en este caso, debido a la inhibición de la enzima por el fenol, el azul de metileno no pudo ser reducido, por.
Azul de Metileno 2 Solución 20 mL Farmacias Cruz Verde

La Succinato deshidrogenasa es la única enzima membranal del ciclo de Krebs. Posee un dominio expuesto a la matriz que es donde ocurre la deshidrogenacción del succinato. Pero el otro dominio está en la membrana y forma parte de la cadena de transporte de electrones respiratoria, por lo que también recibe el nombre de COMPLEJO respiratorio II.
Azul De Metileno Laboratorio EDUCA

Material y métodos: Se realizó un ensayo clínico controlado, aleatorizado, doble ciego. Se estudiaron dos grupos de 30 individuos cada uno: el grupo A recibió azul de metileno en dosis única de 2 mg/kg de peso en 100 cm 3 de solución glucosada al 5% infundida en 60 minutos, y el grupo C (control) recibió 100 cm 3 de solución glucosada al 5% infundida en 60 minutos.
Practica 2 lab 2 La enzima succinato deshidrogenasa o deshidrogenasa del acido succínico es
medir la presencia de dicha enzima en la solución, utilizamos el fenol, para liberar la enzima de hígado, y ver como viraba el color al reducirse el azul de metileno, de las cosas más sorprendentes de esta práctica no fue solo la dificultad encontrada a la hora de hacer los cálculos que nos retrasaron mucho, si no fue también el cómo.
Actividad enzimática de la Succinato Deshidrogenasa 2020 2 Química Orgánica UE Bosque Studocu
La deshidrogenacion del succinato produce FADH El H2 cedido por el succinato puede ser transferido del FADH2 a un colorante susceptible como el azul de metileno que es un sustituyente del aceptor natural de electrones, donde actúa como reductores, que al cambiar su estado redox pasa de coloreado a incoloro o viceversa.
Quimik Azul de Metileno

Práctica 1. Determinación de la Actividad de la Enzima Succinato Deshidrogenasa. Función de cada reactivo. Azul de metileno.-. Tiene la función de ser el aceptor de electrones del complejo succinato-FADH2 Ácido Succinico.-. Tiene la función de reducir al azul de metileno, ya que éste es reducido en lugar del succinato. Aceite de bebé.-.
AGAR EOSINA Y AZUL DE METILENO 450GR MCD LAB Quimex

Succinato deshidrogenasa (SDH), también conocido como el complejo II de la cadena transportadora de electrones, es un complejo proteico mitocondrial con actividad enzimática que funciona tanto en ciclo de Krebs como en la cadena transportadora de electrones ( respiración celular ). Es una enzima que está presente en todas las células.
Pdfpractica3determinaciondeactividaddesuccinatodeshidrogenasaenescherichiacoli
DETERMINACIÓN DE LA ACTIVIDAD DE LA ENZIMA SUCCINATO DESHIDROGENASA.. Succinato/Fumarato +0. Azul de metileno oxidado/ azul de metileno reducido +0. 7 las estructuras del azul de metileno en estado oxidado y reducido. el fenol es : son compuestos que presentan uno o más grupos hidroxi (OH) unidos directamente a un anillo aromáico presenta.
.